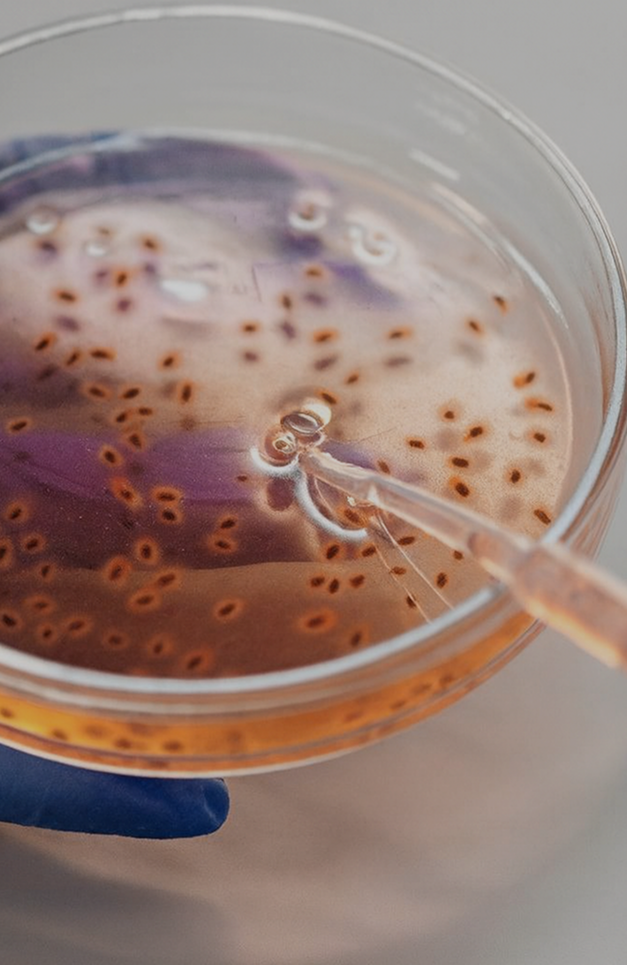
Venture Capital &bull; Venture Capital

Soutenir l’innovation et les entrepreneurs
Venture Capital

Nous finançons les entreprises technologiques à fort potentiel, ancrées dans des thématiques d'avenir. Notre approche combine discipline d'investissement et accompagnement stratégique en co-investissement avec des fonds de référence. Nous donnons aux leaders les moyens d'une croissance exponentielle et durable à l'échelle internationale.



Notre thèse
d'investissement
Accompagner les technologies qui façonnent l’avenir.
1
Technologies
de rupture
IA, climat, industrie
Des marchés vastes et inefficients
Des marchés vastes et inefficients
2
De la vision
à l'exécution
Innovation appliquée
ROI mesurable
ROI mesurable
Early Stage & Growth
Seed à la Série B
1M€ - 5M€
AI
Data
SaaS, cybersécurité, data, infrastructure
Climat
et Tech
climat, énergie, santé, éducation
Manufacturing
4.0
Structure
Seed
à Série B
Stade d’intervention
1M €
à 5M €
Ticket moyen
4 à
8 ans
Horizon d’investissement
Approche
& gouvernance
& gouvernance
Ambra Capital mobilise différents véhicules selon la typologie de projet et le profil investisseur, pour garantir souplesse et sécurité d’exécution.
. . . . . . . . . . . . . .

Sélection
exigeante
exigeante
Nous soutenons des équipes fondatrices solides, expérimentées et alignées sur une vision long terme.
1

Processus
discipliné
discipliné
Chaque décision d’investissement est validée par un comité indépendant, garant de la cohérence stratégique.
2

Gouvernance
structurée
structurée
Nous mettons en place des pactes équilibrés, un reporting régulier et des droits de regard clairement définis.
3

Accompagnement
actif
actif
Nos équipes participent aux boards et accompagnent les fondateurs sur la performance opérationnelle et ESG.
4
ESG
& Innovation
responsable
Chez Ambra Capital, la durabilité guide aussi notre approche du capital-innovation.
Chaque startup est évaluée sur sa capacité à créer de la valeur durable — économique, sociale et environnementale. Nous intégrons systématiquement 4 critères indispensables.
1
Score
ESG
Une notation ESG, adaptée au stade de développement
2
Climat, Inclusion,
Santé, Education
Des objectifs d’impact mesurables
3
Incidences
négatives
Le suivi des incidences négatives (ou PAI) lorsque les données sont disponibles
4
Impact
Analyse des externalités
Exemples de
co-investissements
co-investissements
En France et en Europe
. . . . . . . . . . . . . .

Wandercraft
Série B
Clôturée le 30/09/2019
1,5 M€ levés
Medtech / exosquelette de marche
4 à 6 ans
Actions

Naboo
Série A
Clôturée le 08/03/2024
1,6 M€ levés
Future of Work / plateforme de séminaires d’équipe
4 à 6 ans
Actions

Therapixel
Série B+
Clôturée le 08/12/2025
3,4 M€ levés
Medtech / IA / radiologie (logiciel MammoScreen)
2 à 3 ans
Obligations convertibles en actions

Ledger
Growth / Late stage
Clôturée le 31/12/2021
13,6 M€ souscrits
Digital / Fintech (sécurité crypto-actifs)
4 à 6 ans
Parts de fonds – fonds de private equity
Phagos
Série A
Clôturée le 31/12/2024
3 M€ levés
Santé animale / IA – alternative aux antibiotiques
4 à 6 ans
Actions
Nos réussites partagées





De jeunes start-ups devenues des acteurs majeurs grâce à un accompagnement exigeant et aligné.
Documentation
Vous avez un besoin de financement immobilier ?
Remplissez le formulaire pour que nos équipes analysent votre projet.
Une équipe agile, visionnaire, opérationnelle
Un seul objectif : soutenir nos fondateurs avec une honnêteté sans détour et une attention sincère.
Toutes nos stratégies









